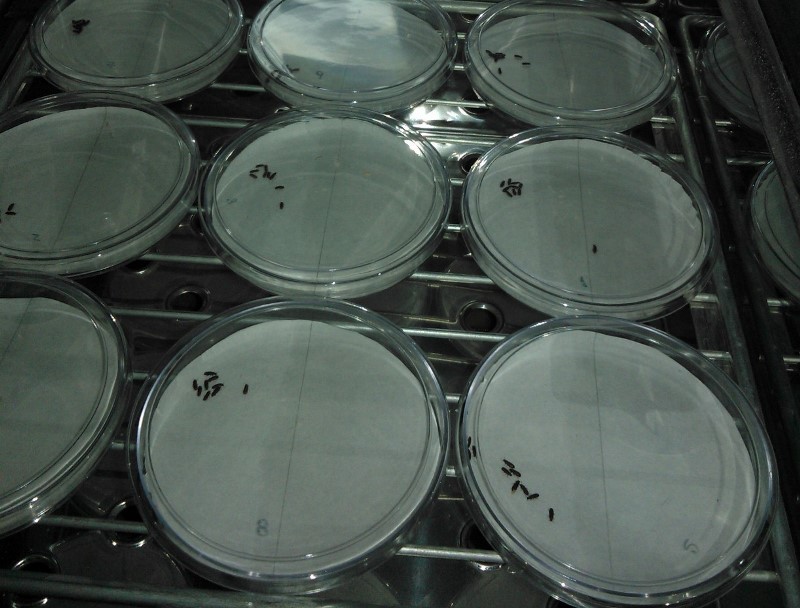

Los gorgojos castaños de la harina (T. castaneum) son una de las plagas más destructivas y extendidas en los granos almacenados y, también, una de las más prevalentes en la región. Debido a que provocan grandes pérdidas, no sólo en la cantidad del producto almacenado, sino también en la calidad, un equipo de investigadores del Conicet y de la Facultad de Ciencias Exactas y Naturales de la Universidad Nacional de La Pampa busca alternativas al control químico de esta plaga.
Desde hace décadas, se utilizan varios tipos de insecticidas sintéticos para el control de las plagas en granos almacenados, “pero su uso frecuente ha inducido resistencia en la mayoría de las plagas”, explicó Anabel Saran, becaria doctoral del Conicet en la Estación Experimental del INTA Anguil –La Pampa–, quien advirtió que “los niveles de residuos de plaguicidas aceptables en granos y oleaginosas limitan las dosis y el uso de estos fumigantes, y el control de plagas se encuentra en una encrucijada”.
En ese sentido, para minimizar la dependencia excesiva de los insecticidas químicos, Saran exploró los metabolitos secundarios de cinco plantas aromáticas nativas de la provincia para desarrollar nuevas alternativas biorracionales al control de gorgojos adultos en granos almacenados.
Si bien las concentraciones en las que deben ser utilizados suelen ser elevadas, los insecticidas botánicos ganaron popularidad, tanto en el manejo integrado de plagas como en la producción agroecológica. Por ejemplo, los aceites esenciales cítricos –subproductos del procesamiento de cítricos– son aceptados en la industria alimentaria por ser seguros y porque muchos cultivos toleran su presencia.
De acuerdo con Saran, “durante el estudio, se pudo determinar que todos los aceites esenciales probados mostraron una alta actividad de repelencia a la concentración más alta establecida y que los aceites esenciales de pichana (B. spartioides) y de girasol silvestre (H. petiolaris) fueron los más eficientes, con 95 % y 92,2 % de repelencia, respectivamente”.
Al mismo tiempo, para analizar la actividad de repelencia en condiciones de campo, se evaluó el comportamiento de la plaga en harina tratada. “En presencia del aceite esencial H. petiolaris, el 90 % de los insectos abandonaron el grano, mientras que B. spartioides indujo un 81 % de emigración”, indicó Saran.
Finalmente, para maximizar los rendimientos en la producción de repelentes, se propuso una mezcla que incluye aceite esencial de limón comercial. “Los resultados obtenidos muestran una diferencia significativa después de 24 horas de tratamiento, donde la repelencia de la mezcla persistió en contraste con los aceites esenciales puros”, precisó Saran.
Las investigadoras aseguraron que los aceites esenciales extraídos de las especies nativas son capaces de controlar la plaga de gorgojos en dosis 10 veces inferiores, en comparación con los productos sintéticos que se utilizan en la actualidad.
Asimismo, Saran aseguró que se trata de una alternativa promisoria debido a que poseen baja toxicidad para los mamíferos, son fáciles de usar, son biodegradables y tienen un impacto reducido en la salud y el ambiente. En este sentido, la especialista del INTA recomendó “la mezcla de los aceites esenciales de B. spartioides y H. petiolaris, con una base del aceite esencial de limón, como el mejor bioproducto”.
La investigación orientada al desarrollo de bioproductos menos tóxicos y amigables con el ambiente, como sustitutos en la protección de granos almacenados, está en aumento y, en ese marco, las especies nativas son un reservorio prometedor.















